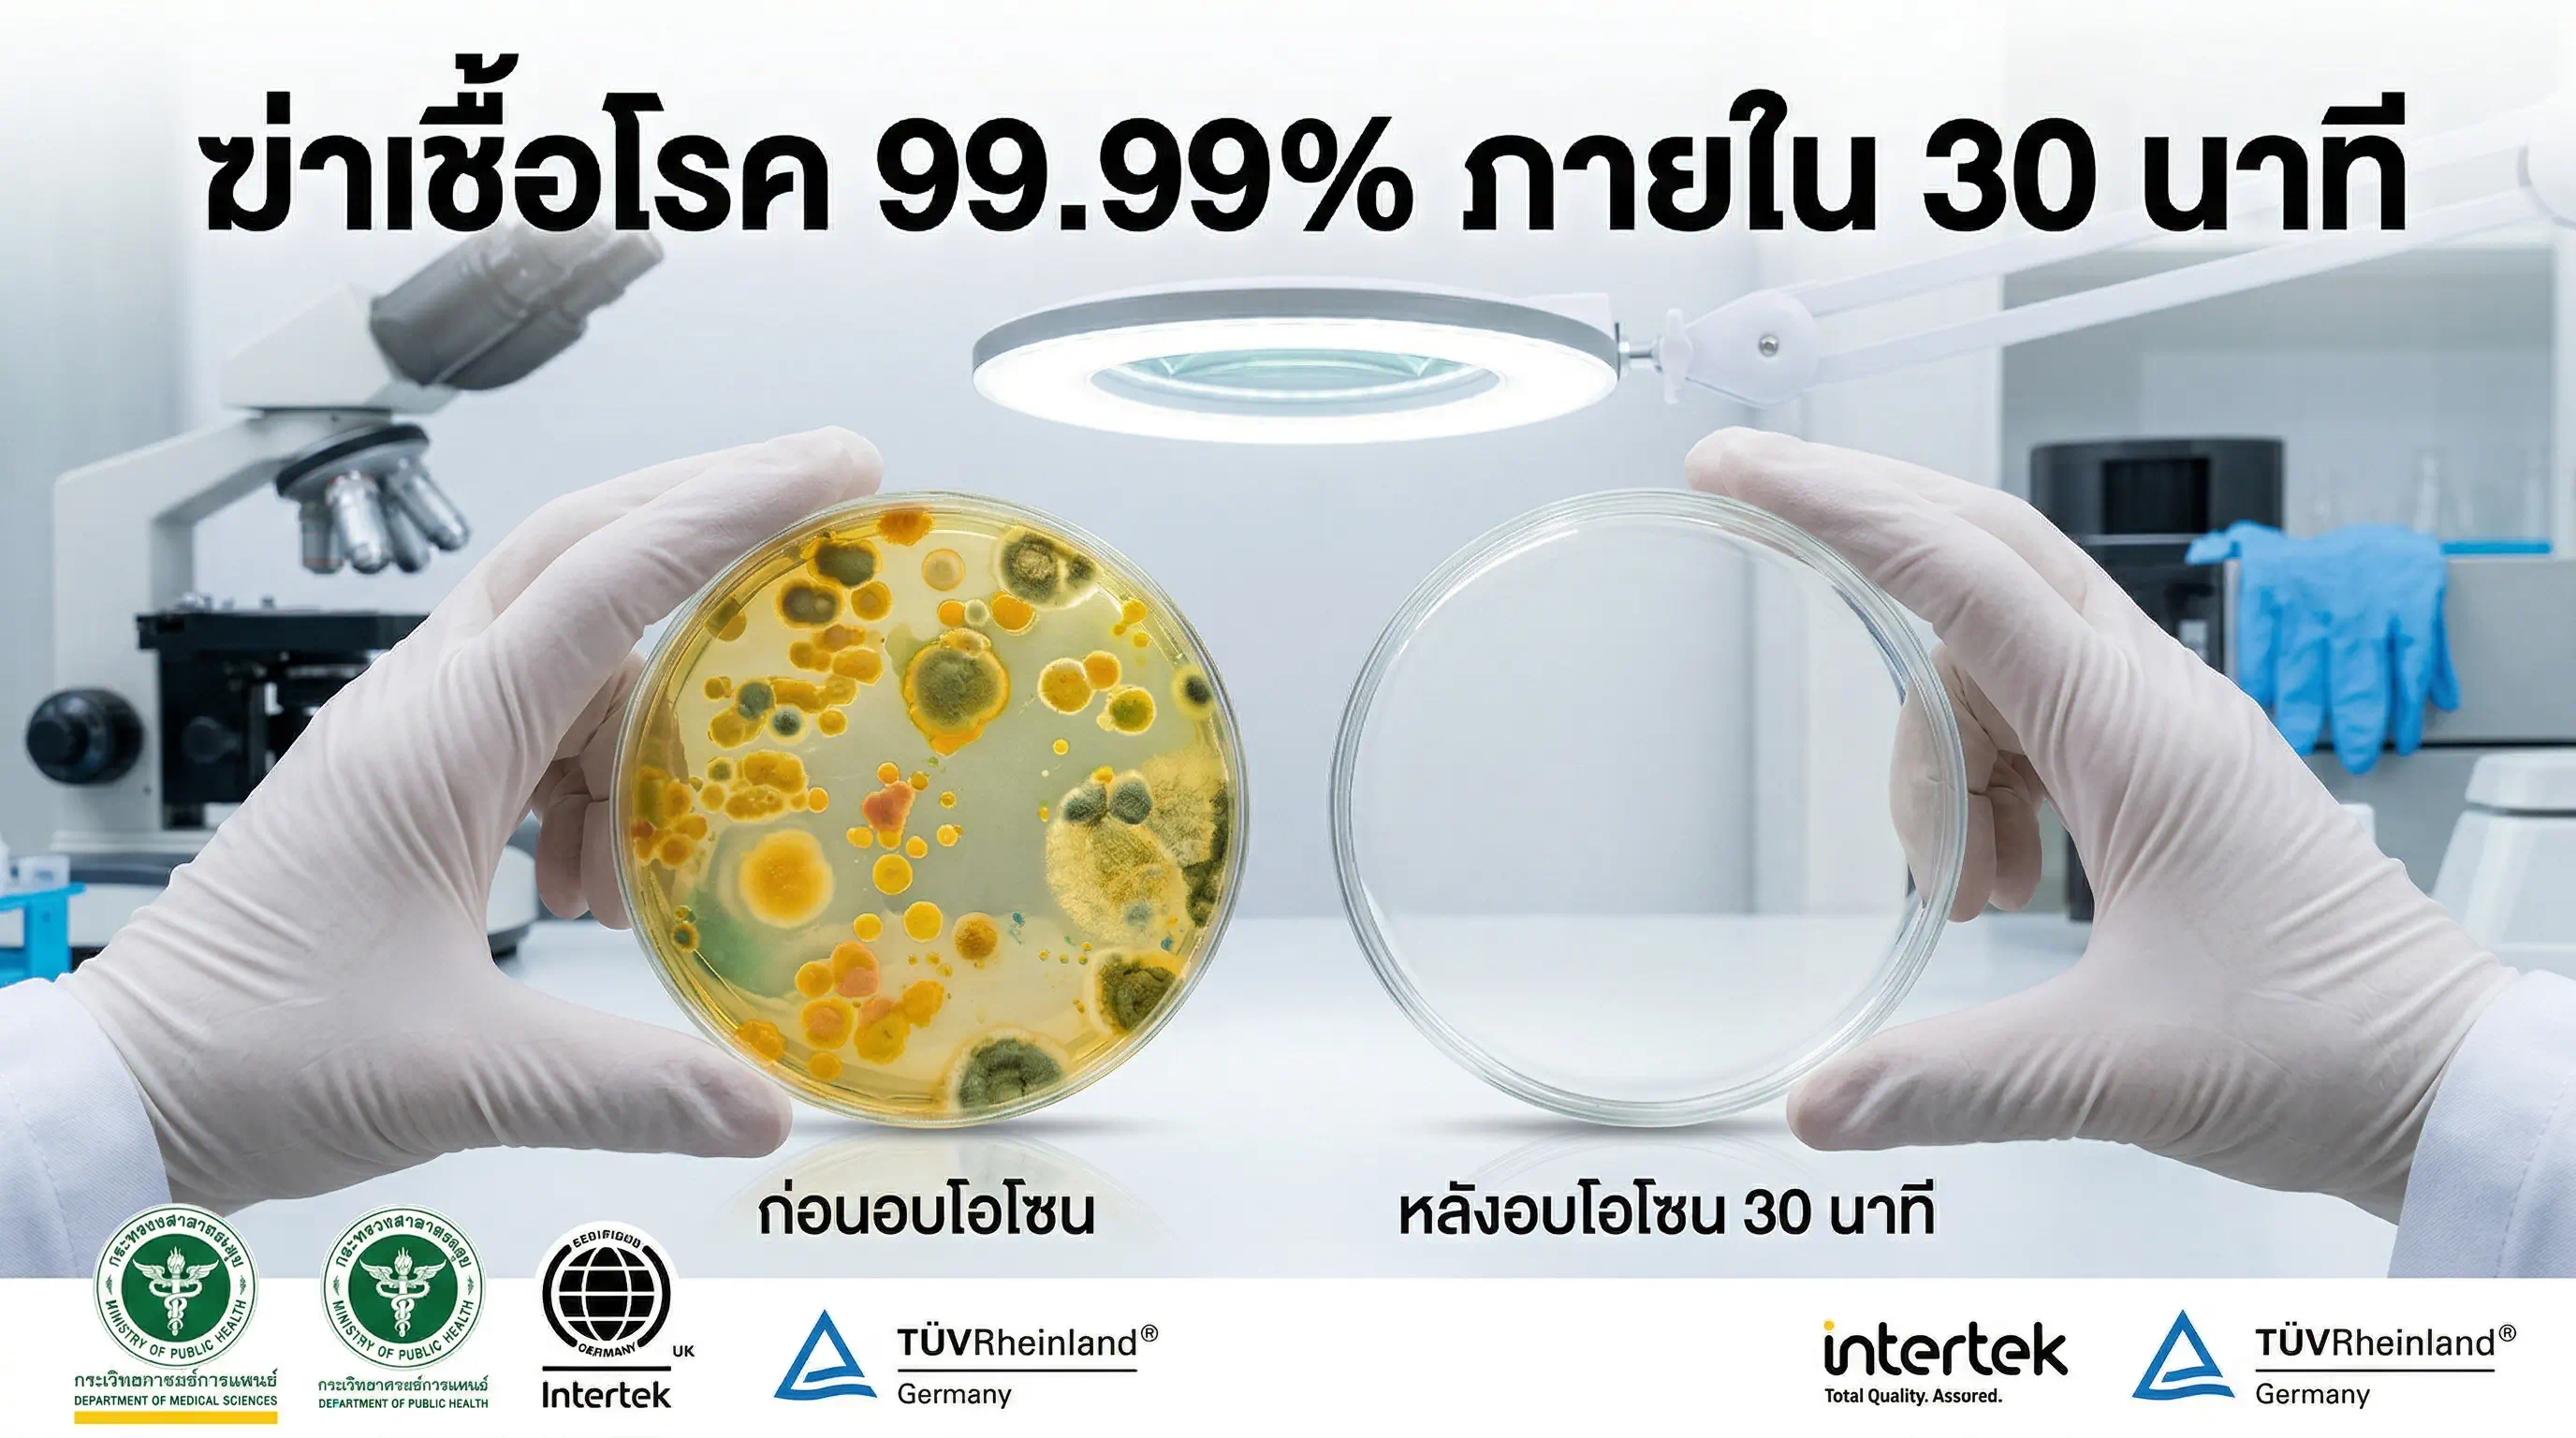

เครื่องสตรีมฆ่าเชื้อ STEMAR
คุณสมบัติสินค้า:
เครื่องสตรีม STEMAR ใช้พลังไอน้ำอุณหภูมิสูงกว่า 100°C ฆ่าเชื้อแบคทีเรีย ไวรัส เชื้อรา และไรฝุ่นบนทุกพื้นผิว ทุกพื้นที่ ทุกหน้างาน ได้จริงโดยมีงานวิจัยระดับนานาชาติรองรับ ไม่มีสารเคมี ไม่มีสารตกค้าง ปลอดภัยทันทีหลังใช้
หมวดหมู่ : เครื่องอบไอน้ำ ,
Share
เครื่องสตรีม STEMAR ใช้พลังไอน้ำอุณหภูมิสูงกว่า 100°C ฆ่าเชื้อแบคทีเรีย ไวรัส เชื้อรา และไรฝุ่นบนทุกพื้นผิว ทุกพื้นที่ ทุกหน้างาน ได้จริงโดยมีงานวิจัยระดับนานาชาติรองรับ
ไม่มีสารเคมี ไม่มีสารตกค้าง ปลอดภัยทันทีหลังใช้

วิทยาศาสตร์เบื้องหลัง ที่พิสูจน์มาแล้วทั่วโลก
เชื้อโรคทุกชนิด ไม่ว่าจะเป็นแบคทีเรีย ไวรัส หรือเชื้อรา ล้วนมีจุดอ่อนร่วมกันอย่างหนึ่ง นั่นคือ ความร้อน
ความร้อนของไอน้ำทำลายโครงสร้างโมเลกุลของจุลินทรีย์ ทำลายผนังเซลล์อย่างถาวร กำจัดได้ทั้งแบคทีเรียอย่าง E. coli และ Salmonella รวมถึงไวรัสอันตรายอย่างไข้หวัดใหญ่และ SARS-CoV-2 (US STEAM)
งานวิจัยที่ตีพิมพ์ในปี 2023 ทดสอบประสิทธิภาพของไอน้ำร้อนต่อเชื้อไวรัส SARS-CoV-2 บนพื้นผิวต่างๆ ทั้งพลาสติก ผ้า และโลหะ พบว่าการใช้หัวพ่นไอน้ำที่ระยะ 1 นิ้ว อุณหภูมิ 194°F เพียง 2 วินาที ก็เพียงพอที่จะกำจัดไวรัสได้หมดสิ้น (US STEAM)
ที่อุณหภูมิระหว่าง 175–212 องศาฟาเรนไฮต์ ไอน้ำสามารถทำลายเชื้อโรคและแบคทีเรียได้ 99% อย่างมีประสิทธิภาพ (Therma-Kleen)
ไม่ใช่แค่คำโฆษณา แต่คือวิทยาศาสตร์ที่ทดสอบซ้ำมาแล้วนับไม่ถ้วน

ฆ่าเชื้ออะไรได้บ้าง?
เชื้อโรคที่ STEMAR กำจัดได้ทั้งหมด เครื่องสตรีม STEMAR ไม่ได้เลือกทำลายแค่เชื้อบางชนิด แต่ ไอน้ำความร้อนสูงสามารถกำจัดได้ถึง 99.99% ของแบคทีเรีย โปรโตซัว เชื้อรา และจุลินทรีย์อื่นๆ บนพื้นผิวที่หลากหลาย (Electrosteam) เชื้อโรค ตัวอย่าง ผลลัพธ์ แบคทีเรีย E. coli, Salmonella, Staphylococcus aureus กำจัดได้ 100% เชื้อดื้อยา (MDR) MRSA, VRE, Pseudomonas aeruginosa กำจัดได้ 100% ไวรัส COVID-19, ไข้หวัดใหญ่, โนโรไวรัส กำจัดได้สมบูรณ์ เชื้อรา Aspergillus, เชื้อราทั่วไป กำจัดได้ ไรฝุ่น & ไข่ไรฝุ่น Dermatophagoides spp. กำจัดได้ 100% สปอร์แบคทีเรีย Clostridium difficile (C. diff) ลดได้อย่างมีนัยสำคัญ งานวิจัยจาก ICU พิสูจน์ว่าไอน้ำมีประสิทธิภาพทัดเทียมกับน้ำยาฆ่าเชื้อ Hypochlorite (คลอรีน) ความเข้มข้นสูงในการกำจัดเชื้อดื้อยา โดยสามารถเข้าถึงพื้นที่ที่การทำความสะอาดแบบดั้งเดิมไม่สามารถเข้าถึงได้ (PubMed Central)

ไอน้ำ vs สารเคมี: ความจริงที่ผู้จัดการสถานที่ต้องรู้
หลายปีที่ผ่านมาอุตสาหกรรมการทำความสะอาดพึ่งพาสารเคมีเป็นหลัก แต่งานวิจัยระดับนานาชาติกำลังชี้ให้เห็นว่านั่นอาจไม่ใช่ทางเลือกที่ดีที่สุด
งานวิจัยเปรียบเทียบพบว่าเทคโนโลยีไอน้ำมีข้อได้เปรียบเหนือกระบวนการทำความสะอาดแบบ 2 ขั้นตอนที่ใช้สารเคมีและ Hypochlorite เพราะหลีกเลี่ยงการใช้สารเคมี ลดการใช้น้ำ ลดเวลาและต้นทุนการทำความสะอาด นอกจากนี้ยังมีต้นทุนถูกกว่าการใช้ Hypochlorite ถึง 76–91% (PubMed Central)
ปัญหาสำคัญของสารเคมีที่หลายคนมองข้าม: สารตกค้างบนพื้นผิว โดยเฉพาะในพื้นที่ที่มีเด็ก ผู้ป่วย หรือผู้สูงอายุ
เชื้อโรคดื้อสารเคมีมากขึ้นเรื่อยๆ (Antimicrobial Resistance หรือ AMR) การใช้ไอน้ำซึ่งใช้เพียงน้ำร้อนไม่ก่อให้เกิดปัญหาเชื้อดื้อยา เพราะทำลายเชื้อโรคด้วยความร้อน ไม่ใช่สารเคมี (Electrosteam)
สารเคมีไม่สามารถเข้าถึงซอกมุมลึกๆ ได้ ในขณะที่ ไอน้ำสามารถแทรกซึมเข้าไปในรอยแตก ซอกหลืบ และรอยต่อที่สารเคมีทั่วไปเข้าไม่ถึงได้ (Fortador)
อันตรายต่อพนักงานที่ใช้งานทุกวัน ระคายเคืองระบบทางเดินหายใจ ผิวหนัง และดวงตา ไอน้ำจาก STEMAR ไม่มีปัญหาเหล่านี้แม้แต่ข้อเดียว

สิ่งที่ทำให้เครื่องสตรีมโดดเด่นคือ ความยืดหยุ่นในการใช้งาน ไอน้ำสามารถใช้ทำความสะอาดและฆ่าเชื้อได้บนพื้นผิวทั้งแบบแข็งอย่างกระเบื้อง พื้นไม้ และเคาน์เตอร์ รวมถึงพื้นผิวอ่อนอย่างเบาะและพรม (Braboscleaning)
โรงแรม & ที่พัก
ที่นอน หมอน เบาะโซฟา ผ้าม่าน พื้นห้องน้ำ กระเบื้อง ราวจับ รีโมทคอนโทรล สวิตช์ไฟ ทุกจุดสัมผัสที่แขกใช้งาน
โรงพยาบาล & คลินิก
ไอน้ำพิสูจน์แล้วว่ากำจัดได้ถึง 99.9% ของเชื้อโรค แบคทีเรีย และจุลชีพก่อโรคในสภาพแวดล้อมของโรงพยาบาล และเป็นตัวเลือกที่คุ้มค่าในแง่เศรษฐศาสตร์ (STI) เหมาะสำหรับเตียงผู้ป่วย อุปกรณ์ทางการแพทย์ พื้นผิวสัมผัส และ ICU
️ร้านอาหาร & ครัวโรงแรม
เตา ตู้เย็น ชั้นวางของ พื้นกระเบื้อง ซอกมุมที่คราบมันสะสม ทำความสะอาดได้โดยไม่ต้องกังวลเรื่องสารเคมีปนเปื้อนอาหาร
โรงเรียน & ศูนย์เด็กเล็ก
ไอน้ำปลอดภัยสำหรับทุกคนในครัวเรือน ตั้งแต่เด็กเล็กจนถึงผู้สูงอายุ ไม่ต้องกังวลว่าสารเคมีจะตกค้างบนของเล่น พื้น หรือโต๊ะที่เด็กสัมผัส (Therma-Kleen)
สปา & ฟิตเนส
เสื่อโยคะ เครื่องออกกำลังกาย ห้องซาวน่า ห้องล็อคเกอร์ พื้นที่ชุ่มชื้นที่เชื้อโรคชอบสะสม
ออฟฟิศ & อาคารสำนักงาน
แป้นพิมพ์ เก้าอี้ พื้นที่นั่งรอ ห้องน้ำรวม ลิฟต์ ทุกพื้นที่ที่คนสัมผัสร่วมกัน
ยานพาหนะ
ภายในรถ เบาะ พวงมาลัย ช่องแอร์ รถบัส รถรับส่งนักเรียน




ไม่ใช่แค่คำโฆษณา แต่มีงานวิจัยรองรับ
งานวิจัยจาก ICU โรงพยาบาลระดับตติยภูมิ (PubMed / PMC):
การศึกษาพิสูจน์ว่าเทคโนโลยีไอน้ำมีประสิทธิภาพเทียบเท่ากับ Hypochlorite ในการกำจัดเชื้อดื้อยา MRSA, VRE, Pseudomonas และ Acinetobacter ในสภาพแวดล้อม ICU และยังประหยัดกว่า ใช้เวลาน้อยกว่า และเป็นมิตรต่อสิ่งแวดล้อมกว่าวิธีเดิม (PubMed Central)
งานวิจัยจาก Queen's University (แคนาดา):
ผลการทดสอบบนเชื้อดื้อยา MRSA, VRE, Pseudomonas aeruginosa, Klebsiella pneumoniae และ Acinetobacter baumannii พบอัตราการกำจัด 100% บนทุกพื้นผิวและทุกชนิดเชื้อ รวมถึงแบคทีเรียที่ซ่อนอยู่ในไบโอฟิล์ม โดยไอน้ำที่ 100°C เพียง 60 วินาทีสามารถกำจัดได้สมบูรณ์ (Intersteam)
งานวิจัยจาก American Journal of Infection Control (AJIC):
รายงานระบุว่า "อุปกรณ์ไอน้ำกำจัดจุลินทรีย์และเชื้อก่อโรคบนพื้นผิวโรงพยาบาลได้อย่างสม่ำเสมอ จนต่ำกว่าระดับที่ตรวจจับได้ในกรณีส่วนใหญ่" (Vapamore)
งานวิจัยจาก ResearchGate (Hospital Cleaning Review):
การทำความสะอาดด้วยไอน้ำเป็นวิธีที่ไม่เป็นพิษต่อร่างกาย รวดเร็ว และสามารถลด Bioburden บนพื้นผิวสภาพแวดล้อมได้มากกว่า 90% พร้อมมีประสิทธิภาพต่อ MRSA, VRE และแบคทีเรียแกรมลบ (ResearchGate)

ทำไมธุรกิจชั้นนำจึงเลือกเครื่องสตรีม?
1. ปลอดภัย 100% ไร้สารเคมี
ไม่มีสารกัดกร่อนหรือสารพิษ สามารถใช้งานได้แม้ในห้องที่มีผู้ป่วยอยู่ ไม่เป็นอันตรายต่อสิ่งแวดล้อมเพราะไม่มีการใช้สารเคมีใดๆ (PubMed Central)
2. ประหยัดน้ำและทรัพยากร
ไอน้ำช่วยลดการใช้น้ำได้ถึงประมาณ 90% เมื่อเทียบกับการทำความสะอาดแบบดั้งเดิม (PubMed Central)
3. ไม่ก่อเชื้อดื้อยา (AMR)
ต่างจากสารเคมีที่ทำให้เชื้อโรคปรับตัวดื้อยามากขึ้นเรื่อยๆ ไอน้ำทำลายด้วยความร้อนล้วนๆ เชื้อโรคปรับตัวต้านความร้อนไม่ได้
4. ใช้ได้ทันทีหลังทำความสะอาด
ไม่ต้องรอให้แห้ง ไม่มีกลิ่นสารเคมีค้าง ไม่ต้องเปิดอากาศถ่ายเท สถานที่สามารถเปิดใช้งานได้ทันที (Fortador)
5. ต้นทุนระยะยาวต่ำกว่า
ไม่จำเป็นต้องซื้อผลิตภัณฑ์ทำความสะอาดหลายชนิด หรืออุปกรณ์ทิ้งแล้วซื้อใหม่บ่อยๆ ช่วยประหยัดเวลาและเงินในระยะยาว (US STEAM)
6. เป็นมิตรต่อผู้แพ้ภูมิแพ้
เหมาะอย่างยิ่งสำหรับผู้ที่มีอาการแพ้ หอบหืด หรือปัญหาระบบทางเดินหายใจ เพราะกำจัดสารก่อภูมิแพ้ได้โดยไม่ต้องใช้สารเคมีใดๆ (Braboscleaning)
7. ยืดหยุ่น ใช้ได้กับทุกพื้นผิว
พื้น ผนัง เพดาน ผ้า เบาะ เครื่องมือ อุปกรณ์ ซอกมุม รอยต่อกระเบื้อง สิ่งที่วิธีอื่นทำไม่ได้ ไอน้ำทำได้
3 เวอร์ชัน เลือกใช้ตามจุดประสงค์
เวอร์ชัน 1 — แบบตรง (Direct)
ถ้าคุณยังใช้สารเคมีในการฆ่าเชื้อ คุณกำลังจ่ายมากกว่าที่ควร และได้ผลน้อยกว่าที่คิด
เครื่องสตรีม STEMAR คือทางเลือกที่โรงแรม โรงพยาบาล และธุรกิจชั้นนำทั่วโลกเปลี่ยนมาใช้ เพราะได้ผลจริง ปลอดภัยกว่า และประหยัดกว่าในระยะยาว
พูดคุยกับทีมงานของเราวันนี้ รับคำแนะนำและใบเสนอราคาฟรี
065-556-6294 | LINE: @whd268
เวอร์ชัน 2 — แบบ Soft (สร้างความสัมพันธ์)
มีคำถามว่า STEMAR เหมาะกับหน้างานของคุณไหม? ทีมงานของเรายินดีให้คำแนะนำโดยไม่มีค่าใช้จ่าย พร้อมข้อมูลประกอบการตัดสินใจทุกอย่างที่คุณต้องการ ตั้งแต่สเปคเครื่อง วิธีใช้งาน ไปจนถึงเอกสารรับรองจากกระทรวงสาธารณสุข
ติดต่อเราได้เลย ไม่มีผูกมัด
เวอร์ชัน 3 — แบบ Urgency (กระตุ้นการตัดสินใจ)
มาตรฐานสุขอนามัยของโลกกำลังเปลี่ยนไป สถานประกอบการที่ยังพึ่งสารเคมีเพียงอย่างเดียวกำลังตามหลังคู่แข่งที่ใช้เทคโนโลยีไอน้ำอยู่แล้ว
อย่ารอให้แขกหรือลูกค้าเป็นคนบอกว่ามาตรฐานของคุณไม่พอ
สอบถามข้อมูล STEMAR วันนี้ก่อนที่คู่แข่งในพื้นที่ของคุณจะทำก่อน
หมายเหตุสำหรับทีมงาน: Content ทั้งหมดนี้สามารถนำไปใส่แต่ละ Section ของ Landing Page ได้เลย โดยแนะนำให้เรียงลำดับ: Hero → ทำไมไอน้ำฆ่าเชื้อได้ → กำจัดอะไรได้บ้าง → เปรียบเทียบกับสารเคมี → พื้นที่ใช้งาน → งานวิจัยรองรับ → ประโยชน์ → CTA ครับ






